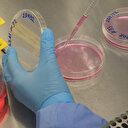

Arşiv
Kayseri Devlet Hastanesi Başhekimi Doç. Dr. İsmail Altıntop; havaların soğumasıyla birlikte vücuda birden fazla virüs girerek solunum yolu enfeksiyonu oluşabileceğini belirterek; "’Tridemi’ dediğimiz birden fazla virüsün bulaştığı enfeksiyonlar bulaşabilir. Tedavi sürecinde vücudumuz virüsü yense bile vücudumuzdaki özellikle boğazımızdaki harabiyetlerin tedavi olması biraz daha uzun sürebilir. Hastalarımızın panik yapmadan tedaviye devam etmelerini öneriyoruz" dedi.
Başhekim Doç. Dr. Altıntop; havaların soğumasıyla birlikte üst solunum yolu enfeksiyonlarında artış olduğunu ifade ederek bu dönemde pandeminin azalmasına rağmen maske kullanımının önemine dikkat çekti.
Grip için tedavilerin yanı sıra ılık bitki çayları, balla karıştırılmış çaylar, papatya, ıhlamur, kuşburnu çayları gibi boğaz mukozasını rahatlatmaya yönelik tedavileri de grip için her zaman önerdiklerini kaydeden Altıntop;
"Kış aylarına girmemizle beraber üst solunum yolu enfeksiyonlarında son dönemlerde belirgin bir artış var. Biliyorsunuz 2019 yılı sonu ile beraber yılının sonuyla beraber covid salgınları oldu ve bu salgınlar da toplum nezdinde birçok değişikliğe neden oldu. Pandeminin azalması ve özellikle maske ve mesafenin bırakılmasıyla birlikte daha önceden maskenin koruduğu enfeksiyonlara karşı da temas eder duruma geldik. Birçok virüsle bundan dolayı da karşı karşıya gelmeye başladık. Özellikle havaların soğumaya başlamasıyla birlikte sonbaharın sonu ile beraber kışın başında virüslerin hastalık yapmaya başladığı dönem olarak her yıl bunu görüyoruz. Maskenin bu dönemde çıkması da virüslerle olan temasımızı artırmış durumda. Gribin; genellikle solunum yolu virüslerin neden olduğu hastalıkların tamamına verilen bir tanım olduğunu bilmemiz gerekiyor. Grip olarak en sık influenza virüslerini, SARS CoV-2 dediğimiz virüsleri, korona virüslerin diğerlerini, parainfluenza ve RSV denilen virüsleri görebiliyoruz. Virüsler solunum yolunda dokulara zara vererek oraya yerleşiyor. Bu bazen bir virüsün değil birden fazla virüsün neden olduğu enfeksiyon halinde karşımıza çıkabiliyor. Vücut birçok virüsle savaşmaya başlıyor ve yeniyor. Virüsü yense, enfeksiyon azalsa bile virüsün vücudumuza verdiği hasarların tedavisi ve yeniden normale dönmesi biraz zaman alıyor. Bu dönemde hastalarımıza biraz sabırlı olmalarını ve orayı rehabilite edici tedaviler kullanmayı öneriyorum. Bunun için de ılık bitki çayları, balla karıştırılmış çaylar, papatya, ıhlamur, kuşburnu çayları gibi toplum nezdinde bilinen ve aslında boğazımızın mukozasını rahatlatmaya yönelik tedavileri grip için her zaman öneriyoruz"
dedi.
"Kronik hastalar daha da dikkat etmeli"
"Kronik hastalar daha da dikkat etmeli"
Kronik hastalığı olanlarda enfeksiyonların daha ağır seyredebildiğinin altını çizen Altıntop;
"Astım, KOAH, diyabeti olan yani kronik rahatsızlığı olan kişilerde ise bu enfeksiyonlar daha ağır seyredebiliyor. Eğer kronik bir akciğer hastalığınız varsa kalabalık ortamlardan uzak durmanızı ve mutlaka maske takmanızı öneriyoruz. Klasik tedavi yöntemlerinin dışında kişinin bireysel olarak kendi hastalığına yönelik tedavi uygulamasını, ilaçlarını düzenli kullanmasını, besin zinciri ve egzersizlere dikkat edilmesini öneriyoruz. Tekrarlayan grip salgınlarının nedeni virüslerdir"
ifadelerini kullandı.
"Birden fazla virüsün bulaştığı enfeksiyonlarda harabiyetlerin tedavi olması biraz daha uzun sürebilir"
"Birden fazla virüsün bulaştığı enfeksiyonlarda harabiyetlerin tedavi olması biraz daha uzun sürebilir"
Birden fazla virüsün neden olduğu enfeksiyonlarda tedavi sürecinin biraz daha uzun sürdüğünü de sözlerine ekleyen Kayseri Devlet Hastanesi Başhekimi Doç. Dr. İsmail Altıntop;
"Aynı kişide bir veya birden fazla olan virüsün etken olduğu hastalık olabilir. 2-3 tane farklı enfeksiyon olabilir. Genellikle bunlar influenza, parainfluenza ve RSV virüsleri dediğimiz virüslerden oluşuyor. Aslında vücut; bu üç virüsle aynı anda savaşabiliyor. Normalde bunların hepsini tek başına yenebilir. Ne zaman bundan şüpheleneceğiz? Özellikle öksürük, boğaz ağrısı, ateş, kas ve eklem ağrıları varsa ’viral enfeksiyon geçiriyoruz’ diyebiliriz. Bu dönemde ’virüse kafa tutmayın mutlaka istirahat edin’ diye bir önerimiz var. Hastalarımızın istirahat etmelerini ve vücut direncini artırıcı besinler tüketmelerini öneriyoruz"
diye konuştu.
#tridemi
#üçlü virüs